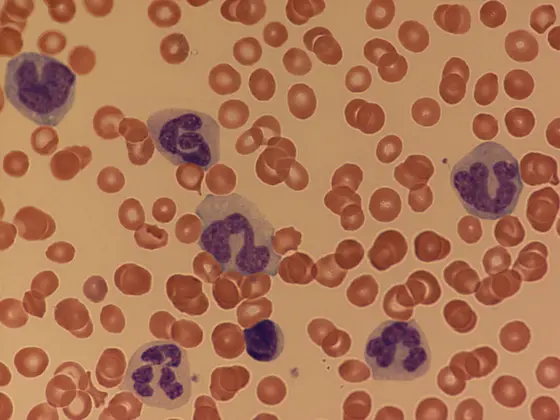
Bei JMML-Patienten enthält das periphere Blut viel zu viele unreife myeloische und monozytäre Zellen.

Bei der juvenilen myelomonozytären Leukämie (JMML) teilen sich die Blutzellen unkontrolliert. An dieser seltenen Form von Blutkrebs erkranken hauptsächlich Kinder, meist noch vor Ende des zweiten Lebensjahrs. Ohne eine Stammzelltransplantation, die bisher einzige Behandlungsform, die den Krebs wirksam bekämpft, verläuft die Erkrankung in den meisten Fällen tödlich.
Bei etwa einem Drittel der transplantierten Patienten kehrt der Krebs zurück. Daher ist es wichtig, bereits frühzeitig exakte Prognosen über den Verlauf der Krankheit zu erstellen. Neueste Ergebnisse der Forscher um Christoph Plass am Deutschen Krebsforschungszentrum (DKFZ) und des Teams um Christian Flotho, Wissenschaftler des Deutschen Konsortiums für Translationale Krebsforschung (DKTK) in Freiburg, können nun dazu beitragen, den Verlauf einer JMML in Zukunft besser einzuschätzen. „Klinische Parameter lassen bisher nur ungenaue Vorhersagen zu“, so Plass. „Umfassende molekulare Analysen wie unsere können helfen, mit größerer Sicherheit vorherzusagen, ob die Therapie anschlägt.“
Die Forscher untersuchten das komplette Erbgut von JMML-Patienten auf das Auftreten von bestimmten Erbgutmarkierungen, den sogenannten DNA-Methylierungen. Die DNA-Methylierung, wie auch andere chemische Modifikationen des Erbguts, werden als „epigenetische“ Veränderungen bezeichnet. Sie steuern die Aktivität einzelner Gene. Im Gegensatz zur genetischen Mutation bleibt die DNA-Sequenz bei der epigenetischen Regulation unverändert.
Die Wissenschaftler entdeckten bei ihrer Analyse, dass sich die JMML-Patienten in drei Gruppen einteilen lassen, je nachdem, wie stark ihre DNA methyliert ist. „Bisher wurde bei der JMML nicht das gesamte Erbgut auf Methylierungen untersucht, sondern lediglich bestimmte Gene“, so Plass.
Die Forscher stellten fest, dass die Patienten, deren Erbgut stark methyliert ist, häufiger Merkmale aufweisen, die mit einem erhöhten Rückfallrisiko nach Stammzelltransplantation verknüpft sind. Dem gegenüber steht eine Patientengruppe, deren Erbgut nur schwach methyliert ist und bei denen die Krankheit milder verläuft. Eine dritte Gruppe weist ein mittleres Maß an Methylierungen auf. „Diese Patienten profitieren von einer Stammzelltransplantation und haben mit der Behandlung meist eine günstige Prognose“, sagt Daniel Lipka, Erstautor der Studie.
„Eine Analyse des Methylierungsstatus der DNA könnte dazu beitragen, den Krankheitsverlauf eines Patienten besser abzuschätzen“, so Lipka. „Wir planen, durch weiterführende Studien mit einer größeren Patientenzahl die drei Gruppen noch genauer zu charakterisieren. Möglicherweise können Therapien dadurch in der Zukunft frühzeitig angepasst werden.“
Daniel B. Lipka, Tania Witte, Reka Toth, Jing Yang, Manuel Wiesenfarth, Peter Nöllke, Alexandra Fischer, David Brocks, Zuguang Gu, Jeongbin Park, Brigitte Strahm, Marcin Wlodarski, Ayami Yoshimi, Rainer Claus, Michael Lübbert, Hauke Busch, Melanie Boerries, Mark Hartmann, Maximilian Schönung, Umut Kilik, Jens Langstein, Justyna A. Wierzbinska, Caroline Pabst, Swati Garg, Albert Catalá, Barbara De Moerloose, Michael Dworzak, Henrik Hasle, Franco Locatelli, Riccardo Masetti, Markus Schmugge, Owen Smith, Jan Stary, Marek Ussowicz, Marry M. van den Heuvel-Eibrink, Yassen Assenov, Matthias Schlesner, Charlotte Niemeyer, Christian Flotho, Christoph Plass: RAS-pathway mutation patterns define epigenetic subclasses in juvenile myelomonocytic leukemia
Nature Communications 2017, DOI 10.1038/s41467-017-02177-w
Ein Bild zur Pressemitteilung zum Download zur Verfügung:
JMML-16-PB.jpg
Bei JMML-Patienten enthält das periphere Blut viel zu viele unreife myeloische und monozytäre Zellen.
Nutzungshinweis für Bildmaterial zu Pressemitteilungen
Die Nutzung ist kostenlos. Das Deutsche Krebsforschungszentrum (DKFZ) gestattet die einmalige Verwendung in Zusammenhang mit der Berichterstattung über das Thema der Pressemitteilung bzw. über das DKFZ allgemein. Bitte geben Sie als Bildnachweis an: „Quelle: Universitätsklinikum Freiburg“.
Eine Weitergabe des Bildmaterials an Dritte ist nur nach vorheriger Rücksprache mit der DKFZ-Pressestelle (Tel. 06221 42 2854, E-Mail: presse@dkfz.de) gestattet. Eine Nutzung zu kommerziellen Zwecken ist untersagt.